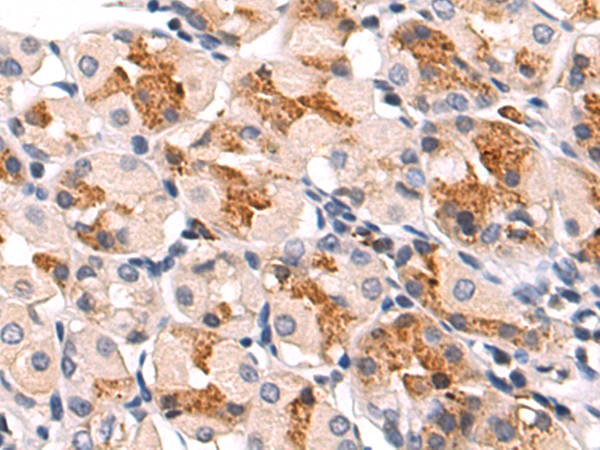

-
分类: 科研抗体货号: P11770别名: PSM; GCP3; FOLH2; FOLHP; PSMAL; GCPIII; PSMA-LIKE应用: IHC反应种属: Human
-
分类: 科研抗体货号: P11794别名: NP60; BM045; HIBDL; N-PAC应用: WB反应种属: Human, Mouse, Rat
-
分类: 科研抗体货号: P11767别名: CASH; FLIP; MRIT; CLARP; FLAME; Casper; FLAME1; c-FLIP; FLAME-1; I-FLICE; c-FLIPL; c-FLIPR; c-FLIPS; CASP8AP1应用: WB,IHC反应种属: Human, Mouse
-
分类: 科研抗体货号: P11793别名: OMIMD1应用: WB,IHC反应种属: Human, Mouse
-
分类: 科研抗体货号: P11766别名: CED-4; FLASH; RIP25应用: IHC反应种属: Human, Mouse
-
分类: 科研抗体货号: P11792别名: GAC; GAM; KGA; GLS1; AAD20应用: WB,IHC反应种属: Human, Mouse, Rat
-
分类: 科研抗体货号: P11765别名: FIH1应用: WB,IHC反应种属: Human, Mouse
-
分类: 科研抗体货号: P11790别名: FAP; GVM; GLML; FAP48; FAP68; FKBPAP; VMGLOM应用: IHC反应种属: Human
-
分类: 科研抗体货号: P11764别名: RHDA2; FGF-20应用: IHC反应种属: Human, Mouse, Rat
-
分类: 科研抗体货号: P11788别名: GIRK3; KIR3.3应用: WB,IHC反应种属: Human, Mouse, Rat

鄂公网安备42018502007531号
鄂公网安备42018502007531号

